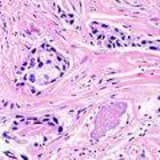

Maintenance
Commit Frequency
Further analysis of the maintenance status of ap-fedex based on released npm versions cadence, the repository activity, and other data points determined that its maintenance is Inactive.
An important project maintenance signal to consider for ap-fedex is that it hasn't seen any new versions released to npm in the past 12 months, and could be considered as a discontinued project, or that which receives low attention from its maintainers.
In the past month we didn't find any pull request activity or change in issues status has been detected for the GitHub repository.